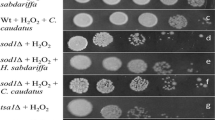

Abstract
Clotrimazole is a type of antifungal medication developed from azole compounds. It exhibits several biological actions linked to oxidative stress. This study focuses on the oxidative effects of clotrimazole on the eukaryotic model yeast, Saccharomyces cerevisiae. Our results showed that although initial nitric oxide levels were above control in clotrimazole exposed cells, they showed decreasing tendencies from the beginning of incubation and dropped below control at 125 µM from the 60th min. The highest superoxide anion and hydrogen peroxide levels were 1.95- and 2.85-folds of controls at 125 µM after 15 and 60 min, respectively. Hydroxyl radical levels slightly increased throughout the incubation period in all concentrations and reached 1.3-fold of control, similarly at 110 and 125 µM in the 90th min. The highest level of reactive oxygen species was observed at 110 µM, 2.31-fold of control. Although NADH/NADPH oxidase activities showed similar tendencies for all conditions, the highest activities were found as 3.07- and 2.27-folds of control at 125 and 110 µM in the 15th and 30th min, respectively. The highest superoxide dismutase and catalase activities were 1.59- and 1.21-folds of controls at 110 µM clotrimazole in 30 and 90 min, respectively. While the drug generally induced glutathione-related enzyme activities, the ratios of glutathione to oxidized glutathione were above the control only at low concentrations of the drug. The levels of lipid peroxidation in all treated cells were significantly higher than the controls. The findings crucially demonstrate that this medicine can generate serious oxidative stress in organisms.
Graphical Abstract

Highlights
-
1.
Clotrimazole treatment enhanced NO• and ROS levels in S. cerevisiae cells.
-
2.
NADH and NADPH oxidases both cause and contribute to ROS generation.
-
3.
The activities of two major antioxidant enzymes, SOD and CAT, were also highly increased.
-
4.
The antioxidant system’s response was insufficient to keep LPO levels under control.
Similar content being viewed by others
Avoid common mistakes on your manuscript.
Introduction
Clotrimazole (1-[(2-chlorophenyl)-diphenylmethyl]imidazole; CLT) is an azole derivative antifungal drug that is effective against a wide range of fungal pathogens (Crowley and Gallagher 2014; Yassin et al. 2023; Feng et al. 2023; Ghahartars et al. 2024). As has been well known for years, the fungistatic mechanism of CLT is associated with the blocking of the synthesis of ergosterol by the inhibition of lanosterol 14 α-demethylase, which belongs to the cytochrome P450 monooxygenase superfamily (Van Den Bossche et al. 1983). Apart from this activity, the studies show that CLT has various biological effects, including disruption of the glycolytic pathway, G1-phase arrest, induction of apoptosis, inhibition of transient receptor potential and calcium-dependent potassium channel, heme-induced membrane damage, and disruption, suppression, and modulation of PI3K/AKT/mTOR, NF-kB, and ERK-p65 pathways, respectively (Jensen et al. 1999; Khanna et al. 1999; Tiffert et al. 2000; Ito et al. 2002; Liu et al. 2023; Kadavakollu et al. 2014; do Nascimento Júnior et al. 2024; Paul et al. 2024). Considering that many of these biological activities are associated with oxidative stress, it becomes vital to understand the effects of CLT on cellular redox status, which can be basically defined as the balance between reactive species (RS) and antioxidant defense mechanisms. A review of the literature shows that CLT induces oxidative stress in different cell types. Trivedi et al. (2005) stated that CLT inhibits the hemoperoxidase of the unicellular protozoan parasite Plasmodium falciparum, and this inhibition is associated with the development of oxidative stress. In a study conducted on breast cancer cells, CLT in combination with the antineoplastic drug paclitaxel increased the level of RS and oxidative stress (Sharma et al. 2017). In a current study, it was reported that CLT treatment leads to actin aggregation, mitochondrial alteration, production of total reactive oxygen species (tROS) and oxidative stress which causes to activation of MAPK signalling pathways in Saccharomyces cerevisiae (Sellers-Moya et al. 2021). Melefa and Nwani (2021) showed that CLT exposure led to an increase in lipid peroxidation (LPO) levels in non-target aquatic species African catfish, such as the Clarias gariepinus. In the same research, it was also demonstrated that while CLT treatment increased catalase (CAT) and superoxide dismutase (SOD) activities, it reduced the glutathione (GSH) level, glutathione reductase (GR), and glutathione peroxidase (GSHPx) activities. Another study showed that CLT influenced the cell membrane potential and permeability in Leishmania donovani, an intracellular parasite of the genus Leishmania that causes leishmaniasis, by producing mitochondrial superoxide (Paul et al. 2024). On the other hand, Pulathan and collegues (2024) stated that CLT demonstrated a protective impact on lung injury in an experimental model of ruptured abdominal aortic aneurysm. This antifungal has been found to be effective for the regression of endometriotic implants through the downregulation of inducible nitric oxide synthase, modulation of the antioxidant defense system, and oxidative stress biomarkers including SOD, GSH and glutathione S-transferase (GST), membrane LPO, and protein carbonylation (Machado et al. 2023). Additionally, a similar disruption effect of CLT therapy on oxidative status has been determined under other kinds of undesirable pathological conditions (Rodrigues Henriques and Gamboa de Domínguez 2012; Osmanağaoğlu et al. 2012; Gao 2024).
In this paper, we aimed to investigate the effects of CLT on the levels of the main RS, namely nitric oxide (NO•), superoxide anions (O2•−), hydroxyl radicals (•OH), hydrogen peroxide (H2O2), and tROS. The changes in the activities of NADH and NADPH oxidase enzymes responsible for the generation of O2•− were detected. In addition, the levels of the main components of the antioxidant defense system, including SOD, CAT, GR, GST, and GSHPx, and the ratio of GSH/GSSG (GSSG is the oxidized form of GSH) were evaluated. Finally, we determined the LPO levels, one of the known markers of oxidative stress status, depend on CLT treatment. We used the wild-type strain of S. cerevisiae as a model organism. This yeast is a non-pathogenic but opportunistic strain, also known as baker’s yeast. The cultivation of S. cerevisiae, whose genome has been fully elucidated, is very simple, rapid, and economical. Furthermore, it has been well known for years that several yeast proteins are functionally interchangeable with highly homologous mammalian proteins, and numerous metabolic pathways, including lipid, protein and energy metabolism, unfolded protein response, prion development, mitochondrial metabolism, and oxidative stress adaptive response, are also conserved in S. cerevisiae yeast (Rinaldi et al. 2010; Barros et al. 2010; Duina et al. 2014; Rouchidane Eyitayo et al. 2021; Zhu et al. 2023). Therefore, the data obtained from the study contribute to the existing literature on the understanding of the CLT-induced oxidative stress mechanism.
Materials and methods
Materials
Unless otherwise stated, all of the chemicals used were analytical or higher purity, obtained from Sigma-Aldrich, Inc. (St. Louis, MO, USA). S. cerevisiae BY4742 wild type strain (MATalpha his3Δ1 leu2Δ0 lys2Δ0 ura3Δ0) was obtained from GE Healthcare Dharmacon, Inc., USA. The measurements were done using Varioskan Flash Spectral Scanning Multimode Reader (Thermo Fisher, USA) and the UV-1700 UV Pharmaspec Spectrophotometer (Shimadzu, Japan).
Cell culture and drug treatment conditions
The yeast cells were routinely grown on yeast-peptone-dextrose-agar medium (YPDA) at 30 0C for 2 days. 1 l of medium consists of 10 g of yeast extract, 20 g of peptone, 20 g of glucose, and 20 g of bactoagar. For the drug treatment, the cells were cultured up to their mid-exponential phase in YPD medium without agar and sub-cultured in 100 ml of the same medium to achieve an optical density (OD) at 660 nm of 0.240, which corresponds to approximately 3.0 × 106 cells per 1 ml. Then, CLT in the concentration range of 50–125 µM was added, and the incubation was carried out for 15–90 min at 30 °C with 180 rpm agitation.
Biochemical assays
At the end of the above-mentioned incubation period, CLT-treated (test groups) and untreated (control groups) cells were harvested after two washing steps with PBS solution at 4 °C and stored in -20 0C until analysis. If the assay needs a supernatant, the cells were homogenized in a Mixer Mill MM 400 (Retsch) for 14 min at a frequency of 30 Hz with glass beads (Carl Roth, 0,25 − 0,5 mm) at a ratio of 1:1, and the samples were kept in an ice bath for 5 min intervals. The obtained samples were stored in -80 0C until analysis.
Determination of the changes in reactive species levels
The levels of O2•− in the test and control groups were determined by using the chemiluminogenic di-acridinium compound bis-N-methylacridinium nitrate (lucigenin), which emits light upon a reaction with O2•− (Skatchkov et al. 1999). In the assay, approximately 3.0 × 105 cells were mixed with 5 µM lucigenin prepared in YPD, and the mixture was incubated at 37 °C for 1 h. The results were expressed as relative luminescence units (RLU).
The procedure described by Barja (1999) was followed with little modification for the determination of H2O2 levels in test and control groups, which is based on the generation of fluorescent biphenyl homovanillic acid (b-HVA) upon oxidation of HVA through the reaction between H2O2 and horseradish peroxidase (HRP). In the assay, 150 µl of yeast cell supernatant was mixed with 1.5 ml of potassium phosphate buffer, which contains 3.0 mM MgCl2, 145 mM KCl, 30 mM HEPES, 0.1 mM EGTA, 0.1 mM HVA, 2.5 mM pyruvate/malate, and 850 U HRP (pH 7.4), and the mixture was incubated at 30 °C for 15 min. Then, 0.5 ml of cold stop solution, which contains 0.1 M glycine and 25 mM EDTA-NaOH, was added to the mixture, and the measurement was carried out at λex = 312 nm and λem = 420 nm. The calculations were made using the calibration curve of H2O2, and the results were expressed as nmol H2O2 per gram of wet weight (nmol/gww).
The procedure described by Kirkland et al. (2007) was followed for the determination of tROS levels in test and control groups by using the fluorescent probe 5-(and-6)-chloromethyl-2′,7′-dichlorodihydrofluorescein diacetate (CM-H2DCFDA, C6827, Invitrogen, Grand Island, NY). In the assay, mid-exponential cells were suspended in YPD medium with 10 µM CM-H2DCFDA (loading medium) and incubated at 28 °C for 1 h. Then, the loading medium was removed, and fresh YPD medium with or without CLT was added. At the end of the drug treatment periods, the measurement was carried out at λex = 485 nm and λem = 528 nm, and the results were expressed as relative fluorescence units (RFU).
The procedure described by Ruenroengklin et al. (2009) was followed with little modification for the determination of •OH levels in the test and control groups, which is based on the generation of a pink color of the malondialdehyde (MDA)-thiobarbituric acid (TBA) product through the release of MDA after the oxidative cleavage of 2-deoxyribose. In the assay, 750 µl of yeast cell supernatant was treated with 750 µl of 10 mM deoxyribose and incubated at 37 °C for 60 min. Then, 500 µl of 1% (w/v) aqueous TBA-trichloroacetic acid (TCA) (pH 7.4) was added to the mixture, and additional incubation was carried out for 30 min at 100 °C. The measurement was carried out at λex = 532 nm and λem = 553 nm against the blank, and the results were expressed as a percentage of the control group.
To determine the levels of NO• in the test and control groups, nitrite (NO2–) levels, which is one of the primary, stable, and nonvolatile breakdown products of NO•, were determined by using Griess reagent, the system based on which a diazotization reaction (Giustarini et al. 2008). In the assay, yeast cell supernatant was mixed with Griess reagent in a ratio of 1:1 and incubated at room temperature for 30 min. The measurement was carried out at 540 nm against the blank, and the calculations were made using the calibration curve of sodium nitrite. The results were expressed as µmol sodium nitrite per gram wet weight (µmol/gww).
Determination of the changes in enzyme activities
The activities of NADH and NADPH oxidases were measured at 340 nm based on the disappearances of NADH and NADPH substrates, respectively (Anders et al. 1970). The calculations were made using the extinction coefficient of 0.00622 l/µmol/cm which is the extinction coefficient of the substrates. One IU was defined as the amount of substrate oxidized per ml of enzyme in a minute.
The SOD activities were measured at 490 nm based on inhibition of the spontaneous autoxidation of 6-hydroxydopamine (6-OHDA) by the action of the enzyme (Crost et al. 1987). One IU was defined as the enzyme amount that required 50% inhibition of 6-OHDA autoxidation.
The CAT activities were measured at 240 nm based on the disappearance of H2O2 by the action of the enzyme (Aebi 1974). The calculations were made using the extinction coefficient of 43.6 M− 1cm− 1 which is the extinction coefficient of H2O2. One IU was defined as the enzyme amount required to decompose one µmole of H2O2.
The GR activities were measured at 340 nm based on the disappearance of NADPH by the action of the enzyme (Massey and Williams 1965). The enzyme activity was calculated using 0.00622 l/µmol/cm, which is the extinction coefficient of NADPH. One IU was defined as the enzyme amount required to oxidize 1 nmol of NADPH per minute at 25 0C.
The GST activities were measured at 340 nm based on the formation of a conjugate between GSH and 1-chloro-2,4-dinitrobenzene (CDNB) by the action of the enzyme (Habig et al. 1974). The enzyme activity was calculated using 0.0096 l/µmol/cm, which is the extinction coefficient of the product. One IU was defined as the enzyme amount required to conjugate 10.0 nmol of CDNB with GSH per minute at 25 0C.
The GSHPx activities were measured at 340 nm based on the disappearance of NADPH by the action of the enzyme (Paglia and Valentine 1967). The enzyme activity was calculated using 0.00622 l/µmol/cm, which is the extinction coefficient of NADPH. One IU was defined as the enzyme amount required to oxidize GSH per minute at pH 7.0 at 25 °C.
Determination of the changes in GSH/GSSG ratios
The GSH/GSSG ratios were calculated by measuring total glutathione (GSH + GSSG) and reduced glutathione (GSH) levels separately and dividing the levels of GSH to GSSG. To measure GSH + GSSG and GSH levels, the procedure reported by Teare et al. (1993) was followed, which is based on the conversion of GSSG to GSH via the action of GR and then monitoring the formation of yellow product through the reaction of GSH with 5,5′-dithiobis-(2-nitrobenzoic acid) (DTNB) at 412 nm. To determine only GSH levels, the GR enzyme solution was removed from the reaction mixture. The calculations were made using the calibration curve of GSH.
Determination of the total protein concentrations
The total protein concentrations were measured using the Bradford method based on the binding of basic proteins with aromatic side chains to Coomassie Brilliant Blue G-250 dye (Bradford 1976).
Determination of the changes in malondialdehyde levels
The MDA levels were measured based on the pink chromogen formation upon reaction with TBA (Schemedes and Holmer 1989). In the assay, 0.5 ml of yeast cell supernatant was mixed with 1.5 ml of 10% TCA, and the mixture was incubated at 90 0C for 15 min. Then, the mixture was centrifuged, and the upper phase was added to the TBA solution in a ratio of 1:1. After additional incubation at 90 0C for 15 min, the measurement was carried out at 532 nm against the blank, and the results were expressed as µmol MDA per gram wet weight (µmol/gww) by using the extinction coefficient of the MDA-TBA product, 1.56 × 105 l/mol/cm.
Statistical analysis
The data are reported as the mean ± SEM of three independent experiments. The differences in variance were analyzed statistically using a two-way analysis of variance (ANOVA), and Tukey’s test was used as a post hoc. GraphPad Prism version 9.5.1 was used for all statistical analyses.
Results and discussion
Determination of the changes in reactive species levels
In this paper, we have firstly examined the changes in the levels of RS, including NO•, O2•−, and •OH radicals, besides tROS and H2O2, in yeast cells depending on the treatment with CLT at 50–125 µM for 15–90 min, the conditions of which the yeast cell death was induced (Kavakcioglu and Tarhan 2018). As can be seen from Fig. 1A, CLT treatment generally caused statistically significant increases in the NO• levels compared to the control for all incubation periods. On the other hand, a time dependent decreasing trend in the initial levels of NO• was observed for all the studied concentrations of the drug. The levels of this radical were found to be under control only for higher concentrations of the CLT after longer exposure periods. The decreases at 125 µM drug treatment for 60 and 90 min were found to be statistically significant (p < 0.05). In a study conducted by Motawi et al. (2015), it was shown that 20 µM CLT alone and its combination with 15 µM imatinib mesylate, a tyrosine kinase inhibitor, statistically significantly increased NO• production compared to the control group after 48 h of treatment in the human breast tumor cell line T47D. In another study, it was similarly reported that the treatment with 25 µM of CLT alone or 25 µM of CLT plus 12.5 nM of the antineoplastic drug paclitaxel for 24 h statistically significantly increased the levels of NO• in the human breast cancer cell lines MCF-7 and MDA-MB-231 (Sharma et al. 2017). Although the treatment periods are longer, it can be stated that these literature data are compatible with our findings by considering the differences in the cell models studied. All these increases in NO• levels can be evaluated as cellular oxidative stress response because of its fast reaction with O2•− to form peroxynitrite (Squadrito and William 1998).
O2•− is mainly generated during the autoxidation of glucose to an enediol radical anion, which is then converted into ketoaldehydes and O2•− radicals (Bozinovski et al. 2015). Our results showed that the levels of this radical almost always statistically significantly increased with the increasing concentration of the drug (p < 0.05), and it reached the highest value of 29.65 ± 0.208 RLU at 125 µM after 15 min. Similarly to the changes in NO• levels, O2•− levels also showed a decreasing trend with an increasing treatment period (Fig. 1B). Additionally, there were positive correlations between the levels of O2•− and NO• for all studied drug concentrations (r50µM=0.995; r75µM =0.984; r110µM =0.932; r125µM= 0.772), which supports the idea that the increases in NO• levels may part of the oxidative stress response system. We did not come across any study reporting the effects of CLT on NO• and O2•− levels together to better understand the roles of these RS in CLT-induced toxicity. Nevertheless, we encountered a paper that demonstrates a significant increase in the fluorescence signal with the O2•− indicator dihydroethdium in yeast after treatment with CLT (Sellers-Moya et al. 2021). The production of O2•− after treatment with another azole antifungal drug, fluconazole, in combination with Lippia origanoides essential oil or thymol was also reported (Zapata-Zapata et al. 2023).
H2O2 is another RS whose levels were investigated in yeast cells depending on the application of the CLT. Although H2O2 is a non-radical RS with a relatively long half-life, it is responsible for the generation of the •OH radical through the Fenton and Haber-Weiss reactions (Halliwell 1991, 2006). In our study, the levels of H2O2 in yeast cells were statistically significantly induced by the increasing concentrations of CLT for all individual treatment periods (p < 0.05) (Fig. 1C). Also, significant changes were recorded for almost all studied concentrations depending on the extension of time. The highest induction was observed at 125 µM treatment for 60 min as 25.58 ± 0,013 nmol.gww− 1, which is approximately 2.9-fold of the related control. Similar inductions were reported in the literature for the fungal strains Phanerochaete chrysosporium, Schizosaccharomyces pombe, and Penicillium chrysogenum treated with menadione, a natural organic compound well known to induce ROS (Emri et al. 1999; Le et al. 1995; Tongul and Tarhan 2014; Criddle et al. 2006; Loor et al. 2010; Sun et al. 2021).
The changes in intracellular •OH levels that depend on CLT treatment are presented in Fig. 1D. As is known, •OH radical is highly reactive and can trigger an overwhelming variety of oxidative reactions. We observed that CLT treatments generally caused statistically significant inductions in •OH levels compared to related controls. Additionally, generally non-significant increases were recorded with prolonged incubation times for each studied dose. As stated above, •OH radicals can be generated via Fenton and Haber-Weiss reactions. As a matter of fact, we found strong negative correlations between •OH and O2•−levels in yeast cells exposed to CLT (r50µM=-0.899; r75µM =-0.941; r110µM =-0.835; r125µM= -0.159). On the other hand, there was no correlation between •OH and H2O2 levels.
The effects of CLT treatments at different concentrations for 15–90 min on NO• (A), O2•− (B), H2O2 (C), •OH (D) and tROS (E) levels of S. cerevisiae cells. Data with error bars show the mean ± S.E.M of three experiments. *p < 0.05 denotes significant differences between control and other studied group by Tukey’s multiple range tests
The levels of tROS as well as specific radical species were also measured in the study. As can be seen from Fig. 1E, tROS levels were statistically significantly induced after 50–125 µM CLT treatment at each treatment period compared to the related controls (p < 0.05). We also observed significant increases at almost all time points of the incubation period for each studied drug dose. The highest increase was recorded at approximately 2.68-fold of the control at 125 µM CLT after 45 min of treatment. It was determined that while there were generally strong positive correlations between tROS and H2O2 levels dependent on both the drug dose and treatment time, these correlations were only found with the increasing concentration of the drug between tROS and other oxygen radicals, namely O2•− and •OH. So, it can be stated that especially non-radical H2O2 is of significance in terms of the intracellular tROS levels in S. cerevisiae exposed to CLT. Similar to our results, 10 µM amphotericin B, which belongs to the polyene class of antifungals, 12.5 µg/ml miconazole, and 104 µM fluconazole, the other two members of azole antifungal agents, led to increases in tROS levels in the range of 2–4 folds after approximately 2–3 h treatment of Candida albicans and Cryptococcus gattii cells, respectively (Ferreira et al. 2013). Moreover, recent studies have proposed a molecular mechanism that is dependent on ROS as the basis for the azole-induced cytotoxicity (de Andrade Neto et al. 2020; Petricca et al. 2023; Lu et al. 2024).
Determination of the changes in NADH and NADPH oxidase activities
The enzymes of NAD(P)H oxidases are known as endogenous ROS producers with their O2•− producing activity from oxygen. The changes in the activities of NADH and NADPH oxidases in S. cerevisiae cells exposed to CLT are presented in Fig. 2A and B, respectively. According to the obtained results, except for 50 µM CLT, both enzyme activities in drug treated groups were generally found to be statistically significantly higher than related control activities throughout the treatment period (p < 0.05). On the contrary, the enzyme activities in the cells treated with 50 µM of the antifungal were lower than control values for all treatment times studied. While the highest NADH oxidase activity was found as 177,91 ± 3.53 U/mg at 125 µM CLT after 15 min of exposure, NADPH oxidase activity reached its maximum at 110 µM CLT after 30 min with a value of 45.87 ± 0.67 U/mg. Furthermore, NADH and NADPH oxidase activity changes showed positive correlations with O2•−levels at the concentration of 125 µM (NADH oxidase-O2•−: r125µM= 0.89 and NADPH oxidase- O2•−: r125µM= 0.68). Our results indicate that fungal NADPH oxidases contribute to the formation of radicals, despite the lack of research on their involvement in antifungal drug-induced ROS (Gonzalez-Jimenez et al. 2023).
The effects of CLT treatments at different concentrations for 15–90 min on NADH (A) and NADPH (B) oxidase enzyme activities of S. cerevisiae cells. Data with error bars show the mean ± S.E.M of three experiments. *p < 0.05 denotes significant differences between control and other studied group by Tukey’s multiple range tests
Determination of the changes in SOD and CAT enzyme activities
We have analyzed the SOD and CAT enzyme activities as the main antioxidant enzymes depending on CLT administration in the present study. While SOD catalyzes the conversion of O2•− to H2O2, CAT catalyzes the decomposition of H2O2 to H2O and O2 (Mandell 1975). In CLT treated yeast cells, SOD enzyme activities were induced compared to the control group, with generally statistically significant differences (Fig. 3A). It was observed that the inductions in SOD activity were insignificant but gradual at 50 and 75 µM CLT treatments as the incubation period increased. The highest value reached 21.37 ± 0.99 U/mg, approximately 1.64-fold of the control, at 110 µM after 45 min of treatment. In a study using green algae cells, it was similarly reported that the antifungals propiconazole, tebuconazole, and myclobutanil significantly increased SOD activity (Nong et al. 2021). As expected, there were strong negative correlations between SOD activities and O2•− levels during the entire incubation period for 50 µM (r50µM=-0.96) and up to 45th min for 75 and 110 µM treatments (r75µM=-0.99; r110µM =-0.88). SOD activities also showed a positive correlation with H2O2 levels at concentrations of 50 and 75 µM (r50µM =0.87; r75µM =0.77). On the other hand, we did not determine any of these correlations at 125 µM, which can be interpreted as a serious deterioration of cellular redox status at higher concentrations of the antifungal.
The effects of CLT treatments at different concentrations for 15–90 min on SOD (A) and CAT (B) enzyme activities of S. cerevisiae cells. Data with error bars show the mean ± S.E.M of three experiments. *p < 0.05 denotes significant differences between control and other studied group by Tukey’s multiple range tests
Similar to the activities of SOD, generally statistically significant increases compared to the control group were recorded in the activities of the CAT enzyme (Fig. 3B). Although slight increases were observed between 0 and 110 µM, approximately similar activities were measured at 125 µM of CLT throughout the treatment time. The highest increase in CAT enzyme activities was obtained approximately 1.22-fold in the sample exposed to 110 M of the drug for 90 min. Because positive correlations were found between CAT activities and H2O2 levels at all studied concentrations (r50µM=0.93; r75µM =0.24; r110µM =0.92; r125µM = 0.66), it is considered that the inductions in the activities of CAT depending on CLT treatment are not sufficient to scavenge H2O2.
Determination of the changes in GSH related antioxidant systems
In the presented paper, the changes in the levels of GSH related antioxidant systems, namely GR, GST, GSHPx activities, and GSH/GSSG ratios, were also determined. The GR enzyme plays a key role in maintaining a reducing environment in the cell by reducing GSSG to GSH. Overall, all investigated exposure times showed statistically significant induction of GR activities in test groups compared to their controls (Fig. 4A). The highest GR activity was found as 252.00 ± 3.89 U/mg at 125 µM drug concentration after 60 min of treatment. On the other hand, a very sharp decrease was observed after an additional 15 min treatment up to approximately 100 U/mg. The negative correlations (r50µM=-0,694; r75µM=-0,872; r110µM=-0,689) between GR enzyme activities and GSH/GSSG ratios reflect that the inductions in GR activity were not sufficient for the regeneration of GSH. GST enzymes catalyze the conjugation reaction of electrophilic xenobiotics with GSH and generate non-toxic polar metabolites from these toxic chemicals. These enzymes also have peroxidase activity, which can reduce the toxicity of hydroxyl-peroxide (Marrs 1996). We found that the enzyme activities were statistically significantly induced in all treatment groups compared to the related controls (p < 0.05) (Fig. 4B). The gradual increases were recorded in the enzyme activities with the increasing concentrations of the drug, and almost all these increases were statistically significant (p < 0.05). GST activity statistically significantly increased at 110 µM throughout all incubation times, and these increases showed strong negative correlations (r=-0,994) with GSH values (data not shown). GSHPx is responsible for the reduction of lipid hydroperoxides and H2O2 to corresponding alcohols and water, respectively, and it is thought to protect the cell against mild oxidative stress (Mates 2000). Similar to the other two enzymes, the GSHPx activities in CLT treated yeast cells were generally higher than those in the control group for all time points, with generally statistically significant differences, and they increased as the drug concentration increases (Fig. 4C). The enzyme activity increased up to approximately 2.56-fold of the control in cells exposed to 125 µM CLT for 30 min. The typical sharp decrease observed in GR and GST enzyme activities was also recorded in GSHPx enzyme activity after 60 min of treatment with 125 µM CLT. Unfortunately, we did not find any significant correlation between GSHPx activity and H2O2 levels.
The effects of CLT treatments at different concentrations for 15–90 min on GR (A), GST (B), GSHPx and GSH/GSSG (D) levels of S. cerevisiae cells. Data with error bars show the mean ± S.E.M of three experiments. *p < 0.05 denotes significant differences between control and other studied group by Tukey’s multiple range tests
These results clearly show that CLT at the studied concentration range induces the activities of these GSH-related enzymes, as observed in SOD and CAT activities. On the other hand, we found that while GSH: GSSG ratios were generally above the control at 50 and 75 µM, they fell below control values in a statistically significant manner at the higher doses of the drug (p < 0.0001) (Fig. 4D). As is well known, the ratio of this redox couple is an important indicator of redox status and oxidative stress. Therefore, it is clear that oxidative stress is dominant in the cell despite the increased antioxidant enzyme activities, especially at relatively high concentrations of the drug. To put it simply, clotrimazole-induced toxicity seems to be linked to a higher level of GSSG. Comparable findings were observed for the antifungals tebuconazole and econazole (Petricca et al. 2023).
Determination of the changes in malondialdehyde levels
The MDA levels in yeast cells treated with CLT are presented in Fig. 5 compared to the untreated control group. As can be clearly seen, these levels statistically significantly increased in CLT exposed yeast cells compared to the untreated control for all studied incubation periods (p < 0.05). The levels reached their maxima by 7.431 ± 0.219 µM MDA/gww in the treatment with 125 µM CLT for 90 min. Hence, it can be clearly stated that the damage to membrane lipids cannot be prevented despite the significant increases in the activities of the main antioxidant enzymes.
A recent study on the juvenile catfish Clarias gariepinus found similar results (Melefa and Nwani 2021). In contrast to our findings, Usul et al. (2006) demonstrated the protective effect of CLT on spinal cord lipid peroxidation. Finally, we came across a study on the effects of fluconazole and itraconazole, other azole-class antifungals. While 0.7 µM itraconazole caused 3-fold increases in LPO levels of the yeast-like fungus Cryptococcus gattii, 104 µM fluconazole did not change the levels after 1 h of treatment (Ferreira et al. 2013).
As a conclusion, the results clearly demonstrated that although increases were observed in the activities of the main antioxidant enzymes compared to their control values, the inductions in radical production could not be prevented and showed their adverse effects on cells with the increases in membrane LPO levels. The drug potentially reduces the defenses of cells, thereby creating opportunities for other oxidative stress-related conditions, such as cellular apoptosis.
Data availability
The data that support the findings of this study are available on request from the corresponding author. The data are not publicly available due to privacy or ethical restrictions.
References
Aebi H (1974) Methods in enzymatic analysis. Catalase H V Bergmeyer, 2nd edn. Academic, New York, pp 674–684
Anders RF, Hogg DM, Jago GR (1970) Formation of hydrogen peroxide by group N streptococci and its effect on their growth and metabolism. Appl Microbiol 19:608–612
Barja G (1999) Measurement of mitochondrial oxygen radical production. In: Yu BP (ed) Methods in aging research. CRC, Boca Raton, FL, pp 533–548
Barros MH, da Cunha FM, Oliveira GA, Tahara EB, Kowaltowski AJ (2010) Yeast as a model to study mitochondrial mechanisms in ageing. Mech Ageing Dev 131(7–8):494–502
Bozinovski S, Vlahos R, Anthony D, McQualter J, Anderson G, Irving L, Steinfort D (2015) COPD and squamous cell lung cancer: aberrant inflammation and immunity is the common link. Brit J Pharmacol. https://doi.org/10.1111/bph.13198
Bradford MM (1976) A rapid and sensitive method for the quantitation of microgram quantities of protein utilizing the principle of protein-dye binding. Anal Biochem 72:248–254
Criddle DN, Gillies S, Baumgartner-Wilson HK, Jaffar M, Chinje EC, Passmore S et al (2006) Menadione-induced reactive oxygen species generation via redox cycling promotes apoptosis of murine pancreatic acinar cells. J Biol Chem 281(52):40485–40492
Crost N, Serviden T, Bayer J, Serra A (1987) Modification of the 6-hydroxydopamine technique for the correct determination of superoxide dismutase. J Clin Chem Clin Biochem 25:265–272
Crowley PD, Gallagher HC (2014) Clotrimazole as a pharmaceutical: past, present and future. J Appl Microbiol 117(3):611–617
de Andrade Neto JB, da Silva CR, Barroso FD, do Amaral Valente Sá LG, de Sousa Campos R, S Aires do Nascimento FB (2020), … Nobre Júnior HV Synergistic effects of ketamine and azole derivatives on Candida spp. resistance to fluconazole. Future microbiology 15(3):177–188
do Nascimento Júnior JX, Sola-Penna M, Zancan P (2024) Clotrimazole reverses macrophage M2 polarization by disrupting the PI3K/AKT/mTOR pathway. Biochem Biophys Res Commun 696:149455
Duina AA, Miller ME, Keeney JB (2014) Budding yeast for budding geneticists: a primer on the Saccharomyces cerevisiae model system. Genetics 197(1):33–48
Emri T, István P, Attila S (1999) Analysis of the oxidative stress response of Penicillium chrysogenum to menadione. Free Radical Res 30:125–132
Feng WY, Cheang UI, Wong KI, Cheong HI, Meng LR, Fong P (2023) Synergistic activity of Coptis Chinensis and clotrimazole against Candida Albicans. Pharmacol Research-Modern Chin Med 8:100287
Ferreira GF, de Matos Baltazar L, Santos JRA, Monteiro AS, de Oliveira Fraga LA, Resende-Stoianoff MA, Santos DA (2013) The role of oxidative and nitrosative bursts caused by azoles and amphotericin B against the fungal pathogen Cryptococcus gattii. J Antimicrob Chemother 114
Gao J (2024) Effect of Clotrimazole suppositories on distribution of pathogens in vaginal secretions and oxidative stress in patients with Vaginitis. Alternative Therapies in Health and Medicine AT10185-AT10185
Ghahartars M, Hosseini H, Khedri M, Sadati MS (2024) Comparison of the efficacies of Topical Liposomal Amphotericin B and Topical Clotrimazole in the treatment of Pityriasis Versicolor. Dermatology Practical Concept 14(1)
Giustarini D, Rossi R, Milzani A, DalleDonne I (2008) Nitrite and nitrate measurement by Griess reagent in human plasma: evaluation of interferences and standardization. Methods Enzymol 440:361–380
Gonzalez-Jimenez I, Perlin DS, Shor E (2023) Reactive oxidant species induced by antifungal drugs: identity, origins, functions, and connection to stress-induced cell death. Front Cell Infect Microbiol 13
Habig WH, Pabst MJ, Jakoby WB (1974) Glutathione S-transferases: the first enzymatic step in mercapturic acid formation. J Biol Chem 249(22):7130–7139
Halliwell B (1991) Reactive oxygen species in living systems: source, biochemistry, and role in human disease. Am J Med Sci 91:14–22
Halliwell B (2006) Reactive species and antioxidants: Redox biology is a fundamental theme of aerobic life. Plant Physiol 141:312–322
Ito C, Tecchio C, Coustan-Smith E, Suzuki T, Behm FG, Raimondi SC, Campana D (2002) The antifungal antibiotic clotrimazole alters calcium homeostasis of leukemic lymphoblasts and induces apoptosis. Leukemia 16:1344–1352
Jensen BS, Ødum N, Jørgensen NK, Christophersen P, Olesen SP (1999) Inhibition of T cell proliferation by selective block of Ca2+ activated K+ channels. P Natl Sci 96:10917–10921
Kadavakollu S, Stailey C, Kunapareddy CS, White S (2014) Clotrimazole as a Cancer Drug: a short review. Med Chem 4(11):722–724. https://doi.org/10.4172/2161-0444.1000219
Kavakçıoğlu B, Tarhan L (2018) Yeast caspase-dependent apoptosis in Saccharomyces cerevisiae BY4742 induced by antifungal and potential antitumor agent clotrimazole. Arch Microbiol 200:97–106
Khanna R, Chang MC, Joiner WJ, Kaczmarek LK, Schlichter LC (1999) hSK4/hIK1, a calmodulin-binding KCa channel in human T lymphocytes roles in proliferation and volume regulation. J Biol Chem 274:14838–14849
Kirkland RA, Saavedra GM, Franklin JL (2007) Rapid activation of antioxidant defenses by nerve growth factor suppresses reactive oxygen species during neuronal apoptosis: evidence for a role in cytochrome c redistribution. J Neurosci 27:11315–11326
Liu X, Gao J, Sun Y, Zhang F, Guo W, Zhang S (2023) Clotrimazole inhibits HCC migration and invasion by modulating the ERK-p65 signaling pathway. Drug Des Dev Therapy 863–871
Loor G, Kondapalli J, Schriewer JM, Chandel NS, Hoek TLV, Schumacker PT (2010) Menadione triggers cell death through ROS-dependent mechanisms involving PARP activation without requiring apoptosis. Free Radic Biol Med 49(12):1925–1936
Lu ZJ, Shi WJ, Ma DD, Zhang JG, Long XB, Li SY, Ying GG (2024) The azole biocide climbazole induces oxidative stress, inflammation, and apoptosis in fish gut. Sci Total Environ 923:171475
Machado DE, Saggioro EM, Junior SFS, Alessandra-Perini J, Diniz LDCG, Coelho WS, Perini JA (2023) Clotrimazole is effective, safe and tolerable for the treatment of endometriosis and functions by downregulating inducible nitric oxide synthase and modulating oxidative stress biomarkers. Mol Cell Endocrinol 564:111883
Mandell GL (1975) Catalase, superoxide dismutase and virulence of Staphylococcus aureus: in vitro and in vivo studies with emphasis on staphylococcal–leukocyte interaction. J Clin Invest 55:561
Marrs KA (1996) The functions and regulation of glutathione-S-transferases in plants. Annu Rev Plant Biol 47(1):127–158
Massey V, Williams CH Jr (1965) On the reaction mechanism of yeast glutathione reductase. J Biol Chem 240(11):4470–4480
Mates JM (2000) Effects of antioxidant enzymes in the molecular control of reactive oxygen species toxicology. Toxicology 153(1):83–104
Melefa TD, Nwani CD (2021) Imidazole antifungal drug clotrimazole alters the behavior, brain acetylcholinesterase and oxidative stress biomarkers in African catfish Clarias gariepinus (Burchell 1822). Comparative Biochemistry and Physiology Part C: Toxicology & Pharmacology 248:109108
Motawi TM, Sadik NA, Fahim SA, Shouman SA (2015) Combination of imatinib and clotrimazole enhances cell growth inhibition in T47D breast cancer cells. Chemico-Biol Interact 233:147–156
Nong QY, Liu YA, Qin LT, Liu M, Mo LY, Liang YP, Zeng HH (2021) Toxic mechanism of three azole fungicides and their mixture to green alga Chlorella pyrenoidosa. Chemosphere 262:127793
Osmanağaoğlu MA, Kesim M, Yuluğ E, Menteşe A, Karahan SC (2012) Ovarian-protective effects of clotrimazole on ovarian ischemia/reperfusion injury in a rat ovarian-torsion model. Gynecol Obstet Invest 74(2):125–130
Paglia DE, Valentine WN (1967) Studies on the quantitative and qualitative characterization of erythrocyte glutathione peroxidase. J Lab Clin Med 70(1):158–169
Paul A, Roy PK, Babu NK, Singh S (2024) Clotrimazole causes membrane depolarization and induces sub G0 cell cycle arrest in Leishmania donovani. Acta Trop 252:107139
Petricca S, Carnicelli V, Luzi C, Cinque B, Celenza G, Iorio R (2023) Oxidative stress, cytotoxic and inflammatory effects of Azoles Combinatorial mixtures in sertoli TM4 cells. Antioxidants 12(6):1142
Pulathan Z, Ergene ŞM, Altun G, Yuluğ E, Menteşe A (2024) Protective effect of clotrimazole on lung injury in an experimental model of ruptured abdominal aortic aneurysm. Adv Clin Exp Med. 2025 https://doi.org/10.17219/acem/182821
Rinaldi T, Dallabona C, Ferrero I, Frontali L, Bolotin-Fukuhara M (2010) Mitochondrial diseases and the role of the yeast models. FEMS Yeast Res 10(8):1006–1022
Rodrigues Henriques JR, Gamboa de Domínguez N (2012) Modulation of the oxidative stress in malaria infection by clotrimazole. Brazilian J Pharm Sci 48:519–528
Rouchidane Eyitayo A, Gonin M, Arokium H, Manon S (2021) Contribution of yeast studies to the understanding of BCL-2 family intracellular trafficking. Int J Mol Sci 22(8):4086
Ruenroengklin N, Yang B, Lin H, Chen F, Jiang Y (2009) Degradation of anthocyanin from litchi fruit pericarp by H2O2 and hydroxyl radical. Food Chem 116:995–998
Schemedes A, Holmer GA (1989) New thiobarbituric acid (TBA) method for determining free malondialdehyde (MDA) and hydroperoxides selectively as a measure of lipid peroxidation. J Am Oil Chem Soc 66:813–817
Sellers-Moya Á, Nuévalos M, Molina M, Martín H (2021) Clotrimazole-induced oxidative stress triggers novel yeast Pkc1-independent cell wall integrity MAPK pathway circuitry. J fungi 7(8):647
Sharma A, Mehta V, Parashar A, Malairaman U (2017) Combinational effect of Paclitaxel and Clotrimazole on human breast cancer: Proof for synergistic interaction. Synergy 5:13–20
Skatchkov MP, Sperling D, Hink U, lsch AM, Harrison DG, Sindermann I, Münzel T (1999) Validation of lucigenin as a chemiluminescent probe to monitor vascular superoxide as well as basal vascular nitric oxide production. Biochem Biophys Res Commun 254:319–324
Squadrito LG, William AP (1998) Oxidative chemistry of nitric oxide: the roles of superoxide, peroxynitrite, and carbon dioxide. Free Radical Bio Med 25:392–403
Sun S, Xu W, Zhang Y, Yang Y, Ma Q, Xu J (2021) Menadione inhibits thioredoxin reductase 1 via arylation at the Sect. 498 residue and enhances both NADPH oxidation and superoxide production in Sect. 498 to Cys498 substitution. Free Radic Biol Med 172:482–489
Teare JP, Punchard NA, Powell JJ, Lumb PJ, Mitchell WD, Thompson RP (1993) Automated spectrophotometric method for determining oxidized and reduced glutathione in liver. Clin Chem 39(4):686–689
Tiffert T, Ginsburg H, Krugliak M, Elford BC, Lew VL (2000) Potent antimalarial activity of clotrimazole in vitro cultures of Plasmodium Falciparum. P Natl Sci 97:331–336
Tongul B, Tarhan L (2014) The effect of menadione-induced oxidative stress on the in vivo reactive oxygen species and antioxidant response system of Phanerochaete chrysosporium. Process Biochem 49:195–202
Trivedi V, Chand P, Srivastava K, Puri SK, Maulik PR, Bandyopadhyay U (2005) Clotrimazole inhibits hemoperoxidase of Plasmodium Falciparum and induces oxidative stress: proposed antimalarial mechanism of clotrimazole. J Biol Chem 280(50):41129–41136
Usul H, Cakir E, Arslan E, Peksoylu B, Alver A, Sayin OC, Baykal S (2006) Effects of clotrimazole on experimental spinal cord injury. Arch Med Res 37:571–575
Van Den Bossche H, Willemsens G, Cools W, Marichal P, Lauwers W (1983) Hypothesis on the molecular basis of the antifungal activity of N-substituted imidazoles and triazoles. Biochem Soc T 11:665–667
Yassin Z, Amirzargar B, Ghasemi R, Valizadeh F, Fattahi M (2023) Comparison of acidifying agents and clotrimazole for treatment of otomycosis: a comprehensive one-way mini-review. Curr Med Mycol 9(2):45
Zapata-Zapata C, Rojas-López M, García LT, Quintero W, Terrón MC, Luque D, Mesa-Arango AC (2023) Lippia origanoides essential oil or thymol in combination with fluconazole produces damage to cells and reverses the azole-resistant phenotype of a Candida tropicalis strain. J Fungi 9(9):888
Zhu YX, Li KJ, He M, Zheng DQ (2023) Research progress in the exploring genomic variations driven by stress factors using the yeast model. Biotechnol Bull 39(11):191
Acknowledgements
This study was supported by Grants from Scientific and Technological Research Council of Turkey (TUBİTAK) with 116Z315 numbered project.
Funding
This study was supported by Grants from Scientific and Technological Research Council of Turkey (TUBİTAK) with 116Z315 numbered project.
Author information
Authors and Affiliations
Contributions
B.K.Y. Data curation, Formal analysis, Methodology, Resources, Writing – original draft, Writing – review & editing.L.T. Methodology, Supervision, Writing – original draft, Writing – review & editing, Resources.
Corresponding author
Ethics declarations
Ethics approval and consent to participate
Not applicable.
Consent for publication
Not applicable.
Competing interests
Berna Kavakc?o?lu Yard?mc? and Leman Tarhan declare that they have no conflict of interest.
Additional information
Communicated by Yusuf Akhter.
Publisher’s Note
Springer Nature remains neutral with regard to jurisdictional claims in published maps and institutional affiliations.
Rights and permissions
Springer Nature or its licensor (e.g. a society or other partner) holds exclusive rights to this article under a publishing agreement with the author(s) or other rightsholder(s); author self-archiving of the accepted manuscript version of this article is solely governed by the terms of such publishing agreement and applicable law.
About this article
Cite this article
Yardımcı, B.K., Tarhan, L. Oxidative effects of the human antifungal drug clotrimazole on the eucaryotic model organism Saccharomyces cerevisiae. Arch Microbiol 206, 290 (2024). https://doi.org/10.1007/s00203-024-04031-2
Received:
Revised:
Accepted:
Published:
DOI: https://doi.org/10.1007/s00203-024-04031-2